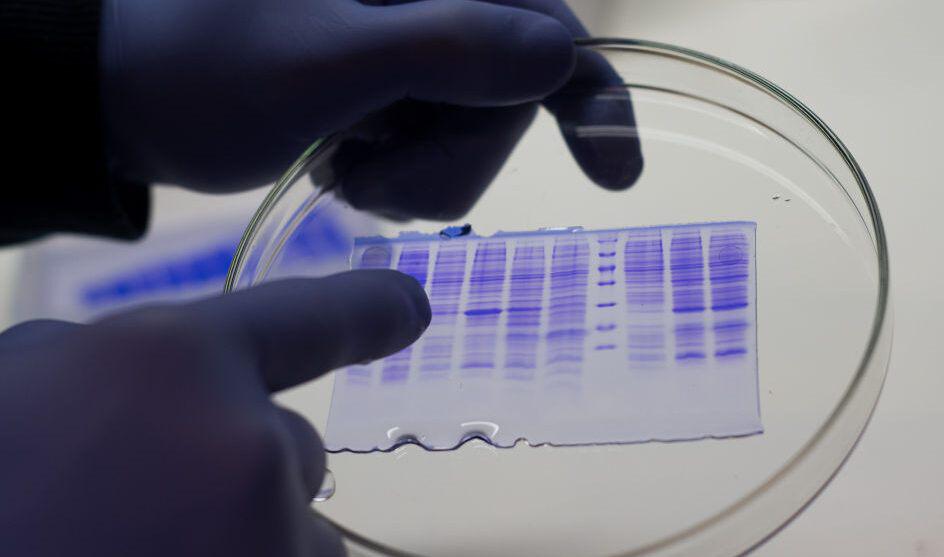

En la mañana del martes, en conferencia de prensa, biotecnólogos de la empresa NOVA, dieron conocimiento del inicio de un desarrollo para enfrentar la pandemia. Se trata de la producción de proteínas con potencial efecto antiviral sobre COVID-19, producto de investigaciones realizadas por el equipo, a través de diversas plataformas de estudio.
Tras el hallazgo, comenzaron con la búsqueda de apoyo de diversos ministerios, para el proceso de ensayo de los antivirales en cuestión. «Tenemos una plataforma lista para empezar a producirlos para ensayos in vitro que se haría desde un instituto virológico, la semana que viene se presentaría la noticia a nivel nacional» explicó entre otros Mauro Piva a periodistas en conferencia de prensa en la mañana del dia martes 14 de julio.
Según relató Piva, «Nova desde hace 8 años ha decidido invertir en biotecnología desarrollando plataformas de microorganismos modificandolos geneticamente para producir diferentes tipos de moléculas: proteínas, enzimas, etc» y respecto de la novedad explicó que «hace muy poco el jefe del equipo de biotecnòlogos, que está conformado por 8 profesionales, nos comunicó que unos de los microorganismos es capaz de producir proteínas que tendrían efecto anti-viral sobre covid«
Obviamente a partir de ese momento la empresa se comunicó con varias instituciones y el gobierno provincial para buscar apoyos que permitan continuar con el desarrollo, y según comentó Piva, «tuvimos un importante apoyo desde la Secretaría de Ciencia, Tecnología e Innovación de la provincia de Santa Fe, que conduce Marina Baima» y agregó que «nos apoyan para continuar con el desarrollo de estos dos antivirales y estamos muy contentos porque tenemos una plataforma lista para empezar a producirlos«
Esta información que solamente tuvo eco en la ciudad de Cañada de Gómez, la semana que viene llegará a los medios nacionales, y por los hasta aquí logrado y si bien restan las pruebas que se realizarían en el Malbrán en lo inmediato, el Ing. Piva, CEO de Nova SA comentó «queremos ser prudentes y no queremos crear falsas expectativas ya que faltan las pruebas que harán en el Malbrán, que sería la última etapa» aunque aclaró que «internamente ya hemos evaluado la performance de estos antivirales con resultados positivos y nos alienta para encarar las ultimas etapas«

Segùn explicó el empresario, este antivural «funciona como un bloqueante entre los receptores de nuestro organismo y el virus y tendría efectivo curativo y no preventivo, pero por supuesto hay que terminar de probarlo«. Puntualmente no sería vacuna, sino sería un antiviral como curativo y no preventivo como lo es la vacuna, y sería administrado para los pacientes con la enfermedad
Ahora, le empresa está a procura de un socio estratégico, para poder asociarse que podía ser una empresa farmacológica para poder lanzar al mercado esta innovación. «Nosotros estaríamos haciendo el desarrollo y planta piloto, la producción en sí la debería hacer una empresa farmacológica. o sea transferiríamos nuestra tecnología» detalló Piva.
«Hoy en el mundo se están evaluando más de 23 vacunas y otros tantos antivirales y nosotros nos sumamos a este grupo para buscar una solución a este problema» dijo el Ing. Mauro Piva y obviamente abre una puerta que coloca a nuestra País y calaramente a la ciudad de Cañada de Gómez a la vanguardia mundial en un tema tan importante.
El equipo, según detalló el empresario, está conformado por 7 biotecnólogos y un licenciado en química, provenientes de 5 universidades diferentes, e inclusive varios de ellos son ex investigadores del CONICET que vinieron a trabajar a Cañada de Gómez.
«Queremos ser muy prudentes, pero a la vez optimistas por los resultados internos obtenidos en laboratorio, pero no manejamos directamente covid pero si lo hemos evaluado en unos kits originarios de USA que simula la reacción de estos dos antivirales en los seres humanos» finalizó Piva.
Edición: Ahora Casilda.



